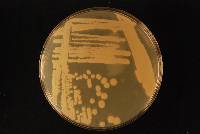
Kluyveromyces marxianus image
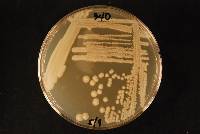
Kluyveromyces marxianus image

System maintenance is ongoing as of Monday, October 27, 2025. The portal is currently set to read only with no changes to content available at this time.
Please contact me at help@mycoportal.org if you have any questions.
Kluyveromyces marxianus
|
|
|
|
Family: Tremellaceae
[Atelosaccharomyces pseudotropicalis (Castell.) Mello, moreBlastodendrion macedoniensis (Castell. & Chalm.) M. Ota, Blastodendrion procerum Zach, Candida kefyr (Beij.) Uden & H.R. Buckley ex S.A. Mey. & Ahearn, Candida macedoniensis (Castell.) Berkhout, Candida macedoniensis var. macedoniensis (Castell.) Berkhout, Candida macedoniensis var. macedoniensoides (Castell.) Westerd., Candida mortifera Redaelli, Candida pseudotropicalis (Castell.) Basgal, Candida pseudotropicalis var. lactosa (F.C. Harrison) Diddens & Lodder, Candida pseudotropicalis var. pseudotropicalis (Castell.) Basgal, Castellania kartulisii (Castell.) C.W. Dodge, Castellania macedoniensis (Castell. & Chalm.) C.W. Dodge, Castellania macedoniensoides (Castell.) C.W. Dodge, Castellania pseudotropicalis (Castell.) C.W. Dodge, Cryptococcus kartulisii Castell., Cryptococcus kefyr (Beij.) C.E. Skinner, Dekkeromyces bulgaricus (Santa María) Kock.-Krat., Dekkeromyces cicerisporus (Van der Walt, E.E. Nel & Kerken) Kock.-Krat., Dekkeromyces fragilis (A. Jörg.) Santa María & Sánchez Nieto, Dekkeromyces macedoniensis (Diddens & Lodder) E.K. Novák & Zsolt, Dekkeromyces marxianus (E.C. Hansen) E.K. Novák & Zsolt, Dekkeromyces muciparus (Beij.) Kock.-Krat., Dekkeromyces wikenii (Van der Walt, E.E. Nel & Kerken) Kock.-Krat., Endomyces pseudotropicalis Castell., Fabospora fragilis (A. Jörg.) Kudryavtsev, Fabospora macedoniensis (Diddens & Lodder) Kudryavtsev, Geotrichoides kefyr (Beij.) Langeron & Talice, Guilliermondella fragilis (A. Jörg.) Boidin, Abadie, J.L. Jacob & Pignal, Guilliermondella marxiana (E.C. Hansen) Boidin, Abadie, J.L. Jacob & Pignal, Hansenula pozolis T. Herrera, Ulloa & C.A. Fuentes, Kluyveromyces bulgaricus (Santa María) Van der Walt, Kluyveromyces cicerisporus Van der Walt, E.E. Nel & Kerken, Kluyveromyces marxianus var. bulgaricus (Santa María) Johannsen & Van der Walt, Kluyveromyces marxianus var. marxianus (E.C. Hansen) Van der Walt, Kluyveromyces marxianus var. wikenii (Van der Walt, E.E. Nel & Kerken) Johannsen & Van der Walt, Kluyveromyces wikenii Van der Walt, E.E. Nel & Kerken, Monilia macedoniensis Castell. & Chalm., Monilia macedoniensis var. macedoniensoides (Castell.) Castell., Monilia macedoniensoides Castell., Monilia mortifera (Redaelli) Nann., Monilia pseudotropicalis (Castell.) Castell. & Chalm., Myceloblastanon kartulisii (Castell.) M. Ota, Myceloblastanon macedoniense (Castell. & Chalm.) M. Ota, Myceloblastanon pseudotropicale (Castell.) M. Ota, Mycocandida mortifera (Redaelli) Langeron & Talice, Mycocandida pinoysimilis var. citelliana Redaelli & Cif., Mycocandida pseudotropicalis (Castell.) Cif. & Redaelli, Mycotorula kefyr (Beij.) F.C. Harrison, Mycotorula lactis Trüper, Mycotorula lactosa F.C. Harrison, Mycotorula macedoniensis (Castell. & Chalm.) Redaelli & Cif., Mycotorula pseudotropicalis (Castell.) Redaelli & Cif., Mycotoruloides macedoniensis (Castell. & Chalm.) C.W. Dodge & M. Moore, Pseudomycoderma mazzae C.W. Dodge, Saccharomyces cavernicola Redaelli, Saccharomyces chevalieri var. atypicus Dietrichson, Saccharomyces fragilis A. Jörg., Saccharomyces fragilis var. bulgaricus Santa María, Saccharomyces fragilis var. fragilis A. Jörg., Saccharomyces fragrans Beij., Saccharomyces kefyr Beij., Saccharomyces kefyr var. kefyr Beij., Saccharomyces macedoniensis Diddens & Lodder, Saccharomyces marxianus E.C. Hansen, Saccharomyces muciparus Beij., Torulopsis kefyr (Beij.) Lodder, Zygofabospora marxiana (E.C. Hansen) Kudryavtsev, Zygorenospora fragilis (A. Jörg.) Krassiln., Zygorenospora marxiana (E.C. Hansen) Krassiln., Zygosaccharomyces ashbyi Cordroch, Zygosaccharomyces marxianus (E.C. Hansen) Guillierm. & Negroni] |
|
|
|
|